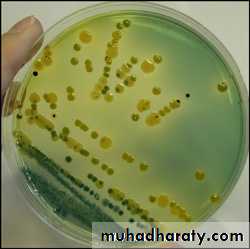

Vibrio cholerae
Vibrio is one of the most common bacteria in surface waters worldwide. They are curved aerobic rods and are motile, by polar flagellum.V cholerae serogroups O1 and O139 cause cholera in humans, and other vibrios may cause skin and soft tissue infections, sepsis, or enteritis.
Typical Organisms:
In first isolation, V. cholerae is a comma-shaped, curved rod.It is actively motile by means of a polar flagellum.
On prolonged cultivation, Vibrios may become straight rods that resemble the G- enteric bacteria.
Vibrio cholerae, motile by polar flagellum
Culture
V cholerae grow well at 37 °C on many kinds of media, including defined media containing mineral salts and asparagines as sources of carbon and nitrogen.V cholerae grows well on thiosulfate-citrate-bile-sucrose (TCBS) agar and alkaline peptone water yellow colonies against the dark-green background of the agar.
Vibrios are oxidase + , which differentiates them from enteric G-bacteria.
,vibrios grow at a very high pH (8.5–9.5) and are killed by acid.
Vibrio cholerae on TCBS
V cholerae ferments sucrose and mannose but not arabinose.
A positive oxidase test result is a key step in the identification of V cholerae and other vibrios.Most Vibrio species are halotolerant, and NaCl often stimulates their growth.
Some vibrios are halophilic, requiring the presence of NaCl to grow.
Growth Characteristics
Antigenic Structure & Biologic Classification1-single flagellar H antigen.
2-V. cholerae has O LPS that confer serologic diagnosis.
There are at least 206 O antigen groups.
V cholerae strains of O group 1 and O group 139 cause classic cholera,
non-O1/non-O139 V cholerae causes cholera-like disease.
Antibodies to the O antigens tend to protect laboratory animals against infections with V .cholerae.
Two biotypes of epidemic V cholerae have been defined, classic and El Tor.
The El Tor biotype produces a hemolysin, gives positive results on the Voges-Proskauer test, and is resistant to polymyxin B.
Vibrio cholerae Enterotoxin
V. cholerae and related vibrios produce a enterotoxin , subunits A and B.
Ganglioside GM1 serves as the mucosal receptor for subunit B, promotes entry of subunit A into the cell.
Activation of subunit A
1-increased levels of intracellular cAMP
2-prolonged hypersecretion of water and electrolytes. 3-increased sodium-dependent chloride secretion,
4- inhibition of absorption of sodium and chloride. Diarrhea occurs—as much as 20–30 L/d—with resulting dehydration, shock, acidosis, and death.
Pathogenesis
Under normal conditions, V cholerae is pathogenic only for humans.A person with normal gastric acidity may have to ingest as many as 1010 or more V cholerae to become infected when the vehicle is water because the organisms are susceptible to acid. When the vehicle is food, as few as 102–104 organisms are necessary because of the buffering capacity of food.
Any medication or condition that decreases gastric acidity makes a person more susceptible to infection with V cholerae.
Cholera is not an invasive infection. The organisms do not reach the bloodstream but remain within the intestinal tract.
Virulent V cholerae organisms attach to the microvilli of the brush border of epithelial cells. There they multiply and liberate cholera toxin and perhaps mucinases and endotoxin.
Clinical Findings
1-About 50% of infections with classic V cholerae and 75% of infections with the El Tor biotype are asymptomatic.The incubation period is 1–4 days for persons who develop symptoms, depending largely upon the size of the inoculum ingested.
2-There is a onset of nausea and vomiting and profuse diarrhea with abdominal cramps.
3-Stools, which resemble "rice water,“ contain mucus, epithelial cells, and large numbers of vibrios.
4-There is rapid loss of fluid and electrolytes, which leads to profound dehydration, circulatory collapse, and anuria.
5-The mortality rate without treatment is between 25% and 50%.
Patient suffer from chlorea, severe dehydration
Diagnostic Laboratory Tests
1-SpecimensSpecimens for culture consist of mucus of stools.
2-Culture
Growth is rapid in peptone agar, on blood agar with a pH near 9.0, or on TCBS agar, and typical colonies can be picked in 18 hours.
3-Specific Tests
V. cholerae organisms are further identified by
slide agglutination tests using anti-O group 1 and group O139 antisera and
by biochemical reaction patterns.
Treatment
1-The most important part of therapy consists of water and electrolyte replacement to correct the severe dehydration and salt depletion.2- Many antimicrobial agents are effective against V. cholerae. Oral tetracycline tends to reduce stool output in cholera and shortens the period of excretion of vibrios.
3-In some endemic areas, tetracycline resistance of V cholerae has emerged; the genes are carried by transmissible plasmids.
4-In children and pregnant women, alternatives to the tetracyclines include erythromycin.
Divisions of V. Cholera
Biotype (biovar)different strains of the same bacterial species
distinguished by a group of phenotypic or genetic traits
Serogroup
bacteria of the same species with different antigenic
determinants on the cell surface
V. Cholera has more than 206 different serogroups, only two of which cause epidemic disease